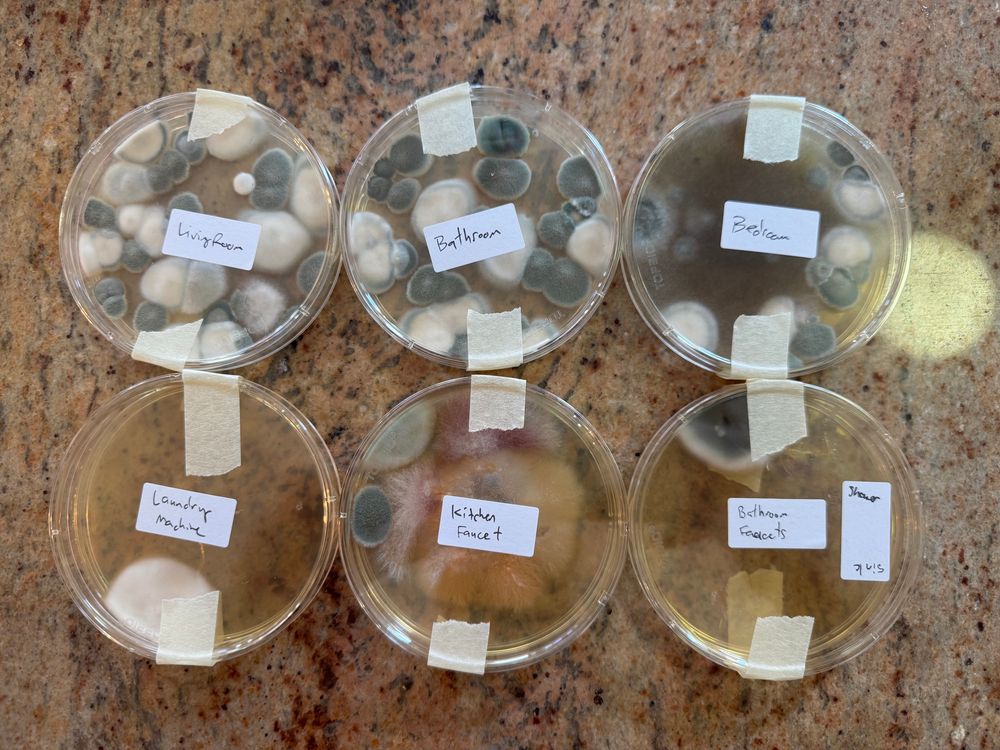
6 Petri dishes measuring mold in my apartment
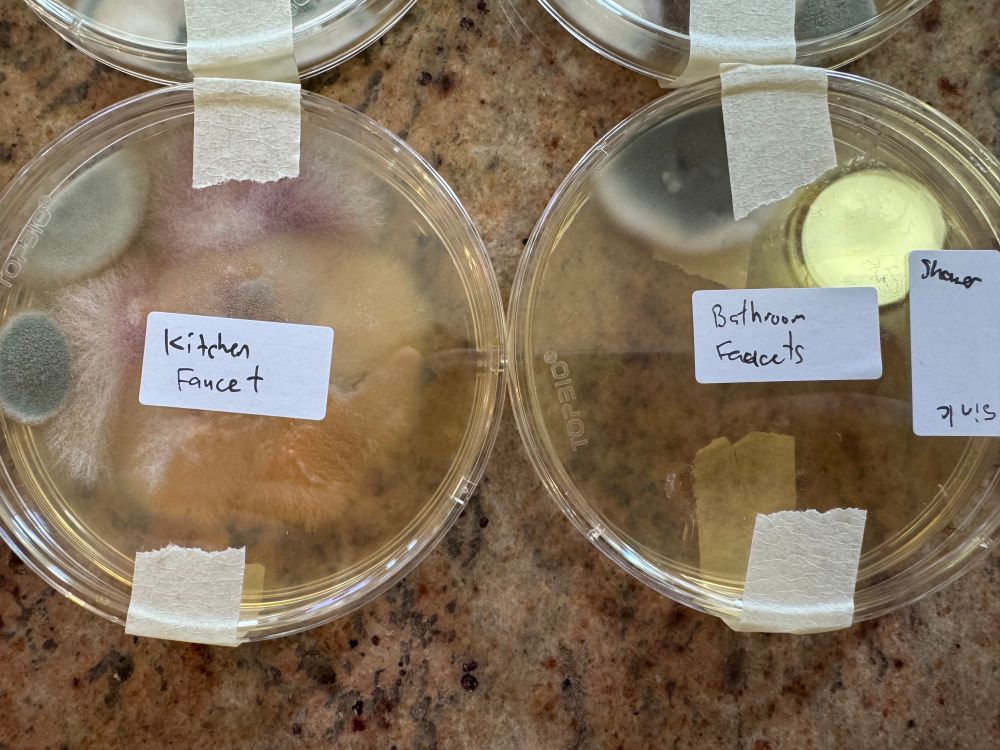
Showing 2 dishes of the Kitchen & bathroom faucets. Kitchen faucet has some red & white fibrous growth

Adam Thompson
@thesonofthomp.com
🇨🇦➡️🗽
Hockey. Hiking. Music. Dogs. Tech.
Sr. UI Engineer at MongoDB
Adam.hasOwnProperty('opinions')
Hockey. Hiking. Music. Dogs. Tech.
Sr. UI Engineer at MongoDB
Adam.hasOwnProperty('opinions')
Abigail Thorn once again knocking it out of the park on Philosophy Tube
And if the cliffhanger ending is too much for you, you can see the next episode on Nebula right now FOR FREE!
go.nebula.tv/philosophytube
go.nebula.tv/philosophytube

Philosophy Tube – Nebula
I'm Abigail, giving away a philosophy degree for free! Subscribe to learn and boost your brain power!
go.nebula.tv
November 8, 2025 at 8:29 PM
Abigail Thorn once again knocking it out of the park on Philosophy Tube
#! #!
Oh, baby, when she moves, she moves
Oh, baby, when she moves, she moves
October 23, 2025 at 2:38 PM
#! #!
Oh, baby, when she moves, she moves
Oh, baby, when she moves, she moves
What are we calling the bite-sized visual interactions generated with MCP-UI? I'm going with "Micro-UI" for now (or µUI for short)
mcpui.dev
mcpui.dev

MCP-UI | Interactive UI Components for MCP
Interactive UI for MCP - Build rich, dynamic interfaces with MCP-UI
mcpui.dev
October 15, 2025 at 2:44 PM
What are we calling the bite-sized visual interactions generated with MCP-UI? I'm going with "Micro-UI" for now (or µUI for short)
mcpui.dev
mcpui.dev
Front Burner with Jayme Poisson: Canada’s bet on an AI boom www.cbc.ca/listen/cbc-p...
October 15, 2025 at 12:49 PM
Front Burner with Jayme Poisson: Canada’s bet on an AI boom www.cbc.ca/listen/cbc-p...
Not sure I agree that “prediction” is the defining aesthetic of our era—gambling and markets have been around for ages.
However this does feel similar to Mark Carney’s idea that we’re moving from a market economy to a Market Society where all of life is commodified
substack.com/@danco/p-175...
However this does feel similar to Mark Carney’s idea that we’re moving from a market economy to a Market Society where all of life is commodified
substack.com/@danco/p-175...

Prediction: the Successor to Postmodernism
The defining reframe of the AI generation
substack.com
October 15, 2025 at 2:27 AM
Not sure I agree that “prediction” is the defining aesthetic of our era—gambling and markets have been around for ages.
However this does feel similar to Mark Carney’s idea that we’re moving from a market economy to a Market Society where all of life is commodified
substack.com/@danco/p-175...
However this does feel similar to Mark Carney’s idea that we’re moving from a market economy to a Market Society where all of life is commodified
substack.com/@danco/p-175...
It feels like the (unspoken) goal of all these companies is to achieve AGI before the bubble pops
Premium: The AI Bubble's promises are impossible. NVIDIA's customers are running out of money, GPUs die in 3-5 years, most 1GW data centers will never get built, and OpenAI's Abilene data center doesn't won't have the power it needs before 2028 - if it ever does.
www.wheresyoured.at/the-ai-bubbl...
www.wheresyoured.at/the-ai-bubbl...

The AI Bubble's Impossible Promises
Readers: I’ve done a very generous “free” portion of this newsletter, but I do recommend paying for premium to get the in-depth analysis underpinning the intro. That being said, I want as many people ...
www.wheresyoured.at
October 15, 2025 at 1:31 AM
It feels like the (unspoken) goal of all these companies is to achieve AGI before the bubble pops
“LLMs often function like a fresh summer intern…who can’t learn”
Having used AI for the last several months, this is my take as well. Actually, our summer intern was much better, and she could learn!
Great piece by @edzitron.com on the reality of the AI market
www.wheresyoured.at/the-case-aga...
Having used AI for the last several months, this is my take as well. Actually, our summer intern was much better, and she could learn!
Great piece by @edzitron.com on the reality of the AI market
www.wheresyoured.at/the-case-aga...

The Case Against Generative AI
Soundtrack: Queens of the Stone Age - First It Giveth
Before we go any further: This is, for the third time this year, the longest newsletter I've ever written, weighing in somewhere around 18,500 wo...
www.wheresyoured.at
October 9, 2025 at 3:42 PM
“LLMs often function like a fresh summer intern…who can’t learn”
Having used AI for the last several months, this is my take as well. Actually, our summer intern was much better, and she could learn!
Great piece by @edzitron.com on the reality of the AI market
www.wheresyoured.at/the-case-aga...
Having used AI for the last several months, this is my take as well. Actually, our summer intern was much better, and she could learn!
Great piece by @edzitron.com on the reality of the AI market
www.wheresyoured.at/the-case-aga...
Did Canada ever have any of our own car companies? I assume if any ever did exist, they were absorbed into the big auto makers in Detroit.
October 8, 2025 at 11:07 PM
Did Canada ever have any of our own car companies? I assume if any ever did exist, they were absorbed into the big auto makers in Detroit.
Lutnick said Canada should acknowledge and understand that "America is first, and Canada can be second,"
Good luck with that
apple.news/AikDqvTC4TDm...
Good luck with that
apple.news/AikDqvTC4TDm...

Canada must come 'second' to U.S. in auto sector, Howard Lutnick warns behind closed doors — Toronto Star
Appearing virtually, the commerce secretary told an audience at a Canada-U.S. conference in Toronto that the U.S. is determined to dominate the car-making industry.
apple.news
October 8, 2025 at 10:50 PM
Lutnick said Canada should acknowledge and understand that "America is first, and Canada can be second,"
Good luck with that
apple.news/AikDqvTC4TDm...
Good luck with that
apple.news/AikDqvTC4TDm...
Wasn’t part of the SAG-AFTRA strike agreement a few years ago supposed to prevent things like “Tilly Norwood”?
September 30, 2025 at 1:32 AM
Wasn’t part of the SAG-AFTRA strike agreement a few years ago supposed to prevent things like “Tilly Norwood”?
Looking for good examples of using UML for frontend, particularly in React. Anyone have any good sources?
September 25, 2025 at 11:18 PM
Looking for good examples of using UML for frontend, particularly in React. Anyone have any good sources?
AI is terrible at writing code in languages I’m experienced in, but seems to be pretty good at languages I’m less familiar with
September 21, 2025 at 10:32 PM
AI is terrible at writing code in languages I’m experienced in, but seems to be pretty good at languages I’m less familiar with
Maturity in design is knowing when to pick your battles

September 5, 2025 at 3:57 PM
Maturity in design is knowing when to pick your battles
It’s pretty embarrassing that while the US is investing in AI and tech infrastructure, Canada is still figuring out how to sell our rocks, trees and oil to countries other than the States
August 29, 2025 at 3:51 AM
It’s pretty embarrassing that while the US is investing in AI and tech infrastructure, Canada is still figuring out how to sell our rocks, trees and oil to countries other than the States
A pyramid scheme that leverages generative AI models: LLMMLM
July 10, 2025 at 11:39 PM
A pyramid scheme that leverages generative AI models: LLMMLM
I’ve been to several book stores looking for a copy of “Moby Dick”, but it seems to be sold out everywhere. I wish there was a literary reference to describe this experience
May 17, 2025 at 6:25 PM
I’ve been to several book stores looking for a copy of “Moby Dick”, but it seems to be sold out everywhere. I wish there was a literary reference to describe this experience
Great analysis by @adamneely.bsky.social Especially loved this quote: “Genre is defined by its ethical code”
youtu.be/R1QEV9euGAg?...
youtu.be/R1QEV9euGAg?...

The Ethics of Fake Guitar
YouTube video by Adam Neely
youtu.be
May 15, 2025 at 3:57 AM
Great analysis by @adamneely.bsky.social Especially loved this quote: “Genre is defined by its ethical code”
youtu.be/R1QEV9euGAg?...
youtu.be/R1QEV9euGAg?...
It will never not be confusing that the uptown E train and the downtown C train both go to JFK

May 13, 2025 at 6:42 PM
It will never not be confusing that the uptown E train and the downtown C train both go to JFK
Mailed my vote a few weeks ago! Let’s keep Kitchener Centre Green @morricemike.bsky.social

April 28, 2025 at 5:36 PM
Mailed my vote a few weeks ago! Let’s keep Kitchener Centre Green @morricemike.bsky.social
Any mycologists able to help me out here?

April 27, 2025 at 4:07 PM
Any mycologists able to help me out here?
Movie you've watched more than six times using gifs.
(“Hard mode” no Star Wars, Star Trek, or LoTR)
(“Hard mode” no Star Wars, Star Trek, or LoTR)
April 26, 2025 at 5:49 PM
Movie you've watched more than six times using gifs.
(“Hard mode” no Star Wars, Star Trek, or LoTR)
(“Hard mode” no Star Wars, Star Trek, or LoTR)
Why do drivers get so defensive when you ask them to not drive 6 inches away from you on your bike?
April 22, 2025 at 4:44 PM
Why do drivers get so defensive when you ask them to not drive 6 inches away from you on your bike?
Can’t wait to be sick of “Panama” by Van Halen in June #GoLeafsGo
April 21, 2025 at 1:36 AM
Can’t wait to be sick of “Panama” by Van Halen in June #GoLeafsGo
Realized I’m giving my dog “duck flavored” treads while at the park, surrounded by ducks. Let’s hope she doesn’t make that connection

April 20, 2025 at 7:28 PM
Realized I’m giving my dog “duck flavored” treads while at the park, surrounded by ducks. Let’s hope she doesn’t make that connection


